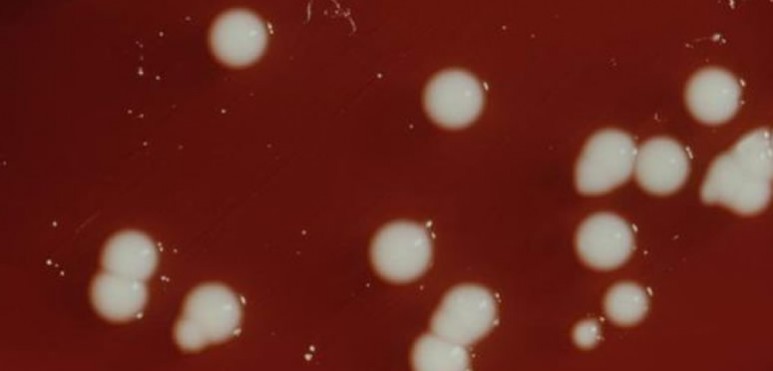

Las nuevas superbacterias se propagan por Europa
Martes 23 de
Julio 2013
En España se pasó de unos "brotes esporádicos hospitalarios" a una "difusión regional"
Las superbacterias se han propagado en los últimos tres años por España y Europa, sobre todo aquellas conocidas -en el mundo medicinal- como enterobacterias, que son resistentes a los antibióticos de última generación (llamados carbepenemos), por lo que su tratamiento hospitalario requiere de mayor inversión. Un informe del Centro Europeo para la Prevención y el Control de Enfermedades (ECDC) revela que en el ámbito nacional se ha pasado de "brotes esporádicos" a una "difusión regional".
Para el microbiólogo España "está muy lejos" del nivel de Italia o Grecia, que junto a Malta son los únicos países en situación "endémica". Sin embargo, también no es posible compararse con las naciones nórdicas, que ocupan los primeros lugares. Islandia es el único país donde no se han registrado brotes.
La diferencia con los países nórdicos reside en la utilización de los antimicrobianos. "Hay una correlación, a mayor uso de antibiótico, mayor la resistencia de las bacterias", afirmó Cantón, que es jefe del Servicio de Microbiología del Hospital Universitario Ramón y Cajal en Madrid.
España está entre los primeros diez países de Europa en consumo de antibióticos. Datos del Ministerio de Sanidad muestran que diariamente 20 personas, de cada 1.000, toman antibióticos fuera del sistema hospitalario. Los más consumidos son las penicilinas, seguidos por las quinolonas, macrólidos y cefalosporinas.
Para Cantón los médicos deben trabajar con los microbiólogos para "conocer mejor" los antibióticos y recetarlos cuándo sean necesarios, en la dosis correcta y el tiempo mínimo posible, aunque aclaró: "No quiere decir que los antibióticos se están usando mal, sino que se puede mejorar su utilización".
Las superbacterias se adquieren únicamente en los hospitales por el contacto entre los pacientes, o entre estos y los miembros del equipo sanitario o los utensilios. Los más propensos son aquellos que previamente han recibido un tratamiento con antibióticos o que tienen el sistema inmune debilitado porque están en terapias inmunosupresoras.
En la batalla contra las superbacterias una de las desventajas de los equipos médicos es que se ha detenido la innovación de antibióticos. "Hasta ahora la comunidad científica estaba tranquila, decía: 'Hay una resistencia pero hay un antimicrobiano que evita esa defensa", comentó Cantón, para quien "ahora" el proceso de invención es cada vez más complicado, largo y costoso, por lo que las compañías farmacéuticas "es muy poco probable" que retomen la inversión en ese campo.
Las superbacterias más comunes son las Klebsiella pneumoniae y Escherichia coli (causa común de infecciones urinarias y respiratorias). En el pasado las más populares fueron la Estafilococo áureo (resistente a la meticilina, la llamada MRSA) o la llamada Visa (Estafilococo áureo) inmune a la vancomicina, que en 1999 era el antibiótico más fuerte con que constaban los médicos.
Otra desventaja del sistema sanitario es que los casos de superbacterias no son de declaración obligatoria, según el experto, por lo que se carece de una base de datos "en tiempo real", que ayude a saber la dimensión de un brote y establecer las medidas epidemiológicas más adecuadas.
La diferencia con los países nórdicos reside en la utilización de los antimicrobianos. "Hay una correlación, a mayor uso de antibiótico, mayor la resistencia de las bacterias", afirmó Cantón, que es jefe del Servicio de Microbiología del Hospital Universitario Ramón y Cajal en Madrid.
España está entre los primeros diez países de Europa en consumo de antibióticos. Datos del Ministerio de Sanidad muestran que diariamente 20 personas, de cada 1.000, toman antibióticos fuera del sistema hospitalario. Los más consumidos son las penicilinas, seguidos por las quinolonas, macrólidos y cefalosporinas.
Para Cantón los médicos deben trabajar con los microbiólogos para "conocer mejor" los antibióticos y recetarlos cuándo sean necesarios, en la dosis correcta y el tiempo mínimo posible, aunque aclaró: "No quiere decir que los antibióticos se están usando mal, sino que se puede mejorar su utilización".
Las superbacterias se adquieren únicamente en los hospitales por el contacto entre los pacientes, o entre estos y los miembros del equipo sanitario o los utensilios. Los más propensos son aquellos que previamente han recibido un tratamiento con antibióticos o que tienen el sistema inmune debilitado porque están en terapias inmunosupresoras.
En la batalla contra las superbacterias una de las desventajas de los equipos médicos es que se ha detenido la innovación de antibióticos. "Hasta ahora la comunidad científica estaba tranquila, decía: 'Hay una resistencia pero hay un antimicrobiano que evita esa defensa", comentó Cantón, para quien "ahora" el proceso de invención es cada vez más complicado, largo y costoso, por lo que las compañías farmacéuticas "es muy poco probable" que retomen la inversión en ese campo.
Las superbacterias más comunes son las Klebsiella pneumoniae y Escherichia coli (causa común de infecciones urinarias y respiratorias). En el pasado las más populares fueron la Estafilococo áureo (resistente a la meticilina, la llamada MRSA) o la llamada Visa (Estafilococo áureo) inmune a la vancomicina, que en 1999 era el antibiótico más fuerte con que constaban los médicos.
Otra desventaja del sistema sanitario es que los casos de superbacterias no son de declaración obligatoria, según el experto, por lo que se carece de una base de datos "en tiempo real", que ayude a saber la dimensión de un brote y establecer las medidas epidemiológicas más adecuadas.
Con información de
El País
POLÍTICA
Goity: el músculo político baja… y el peso de las fotos también
Cuando un gobierno pierde volumen político, se nota… y bastante.
Senadores recibieron a Ministros para evaluar tres importantes proyectos de ley
Se trata de la prohibición de toda actividad relacionada al cuidado de vehículos en la vía pública; de la modificación del art.66 del del Código Procesal Penal Juvenil; y de la adhesión a la Ley Nacional 27786: Organizaciones criminales

Suscribite!
Y recibí las noticias más importantes!
Y recibí las noticias más importantes!
Nota22.com
Conducen: Maxi Romero y Carlos Renna
LO MÁS VISTO
Goity: el músculo político baja… y el peso de las fotos también
Cuando un gobierno pierde volumen político, se nota… y bastante.
El ministro estaría perdiendo apoyo de dirigentes con los que llegó a la cartera. Además, existiría un clima laboral atravesado por diferencias políticas que acentúan la grieta interna.
¿Podemos preguntarlos qué similitudes y diferencias encontramos en la justicia terapéutica y la restaurativa?
¿Cuáles son los desafíos actuales de la justicia?




